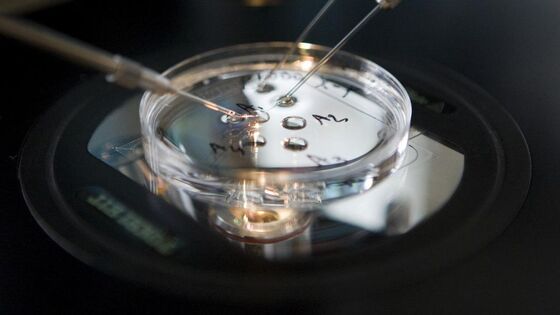
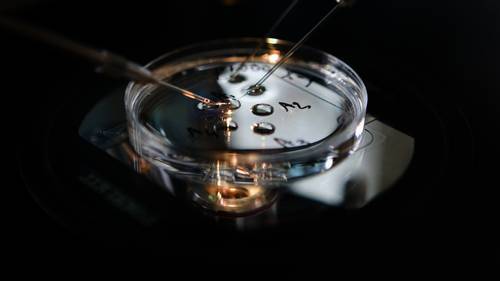

Actueel
Op deze pagina treft u alle nieuwsberichten, publicaties, video's e.d.
Jouw gekozen filters:
Oefen gezag uit om anderen te dienen, niet om te heersen.
Bernard van Clairvaux
Wie zich het verleden niet kunnen herinneren, zijn ertoe veroordeeld dat te herhalen.
George Santayana
Die op den HEERE vertrouwen, zijn als de berg Sion, die niet wankelt, maar blijft in eeuwigheid. Rondom Jeruzalem zijn bergen; alzo is de HEERE rondom Zijn volk, van nu aan tot in der eeuwigheid.
Psalm 125 vers 1 en 2
Gerechtigheid verhoogt een volk, maar de zonde is een schandvlek der natiën.
Spreuken 14 vers 34
Maar wij verwachten, naar Zijn belofte, nieuwe hemelen en een nieuwe aarde, in dewelke gerechtigheid woont.
2 Petrus 3 vers 13
Wordt door het kwade niet overwonnen, maar overwint het kwade door het goede.
Romeinen 12 vers 21
Vertrouw het verleden toe aan Gods barmhartigheid, het heden aan Zijn liefde en de toekomst aan Zijn voorzienigheid.
Aurelius Augustinus (354-430)
Het principiële individualisme is niets anders dan de voltooide liefdeloosheid.
K.H. Miskotte
De geloofsuitspraak dat God de Schepper is van hemel en aarde is een motie van vertrouwen.
A. van de Beukel
Vrees God, en houd Zijn geboden, want dit betaamt alle mensen. Want God zal ieder werk in het gericht brengen, met al wat verborgen is, hetzij goed, of hetzij kwaad.
Prediker 12: slotsom
Angst is de hoogtevrees van de vrijheid.
Sören Kierkegaard
Maar de vrucht des Geestes is liefde: blijdschap, vrede, lankmoedigheid, goedertierenheid, goedheid, geloof, zachtmoedigheid, matigheid.
Galaten 5 vers 22
Die rechtvaardigheid en weldadigheid najaagt, zal het leven, rechtvaardigheid en eer vinden.
Spreuken 21 vers 21
De lankmoedige is beter dan de sterke; en die heerst over zijn geest, dan die een stad inneemt.
Spreuken 16 vers 32
Indien dan de Zoon u zal vrijgemaakt hebben, zo zult gij waarlijk vrij zijn.
Johannes 8 vers 36
De God van Adam is de God van A’dam.
Okke Jager
Een goede herder scheert zijn schapen, maar vilt ze niet.
Suetonis
De goedertierenheid en waarheid zullen elkander ontmoeten; de gerechtigheid en vrede zullen elkander kussen. De waarheid zal uit de aarde spruiten, en gerechtigheid zal van den hemel nederzien.
Psalm 85 vers 11 en 12
Wie geen regels kent, is een dwaas, maar wie geen uitzonderingen kent is dubbel zot.
J. Overduin
Wijsheid is beter dan kracht.
Prediker 9 vers 16
Wie het gezag van God verwerpt, erkent op den duur ook niet meer het gezag van mensen.
ds. H.G. Abma (1917-1992)
De vreze des HEEREN is het beginsel der wijsheid, allen, die ze doen, hebben goed verstand; Zijn lof bestaat tot in der eeuwigheid.
Psalm 111 vers 10
De grootste misrekenaars in het leven zijn zij die alles willen berekenen.
C. Rijnsdorp
Wentel uw weg op den HEERE, en vertrouw op Hem; Hij zal het maken; en zal uw gerechtigheid doen voortkomen als het licht, en uw recht als den middag.
Psalm 37 vers 5 en 6
Een land waar allen vrij zijn om alles te doen, verliest de echte vrijheid.
O. Noordmans
De HEERE zal in eeuwigheid regeren; uw God, o Sion! is van geslacht tot geslacht. Hallelujah!
Psalm 146 vers 10
Hoop heeft twee dochters: woede en moed. Woede over de situatie zoals zij is en de moed om er iets aan te veranderen.
Aurelius Augustinus (354-430)
Wie niet in wonderen gelooft, is geen realist.
David Ben Goerion
De hele geschiedenis is onbegrijpelijk zonder Christus.
Ernest Renan
Offert offeranden der gerechtigheid, en vertrouwt op den HEERE. Velen zeggen: Wie zal ons het goede doen zien? Verhef Gij over ons het licht Uws aanschijns, o HEERE!
Psalm 4 vers 6 en 7
Maar de wijsheid, die van boven is, die is ten eerste zuiver, daarna vreedzaam, bescheiden, gezeglijk, vol van barmhartigheid en van goede vruchten, niet partijdig oordelende, en ongeveinsd. En de vrucht der rechtvaardigheid wordt in vrede gezaaid voor degenen, die vrede maken.
Jakobus 3 vers 17 en 18
Hij heeft u bekend gemaakt, o mens! wat goed is; en wat eist de HEERE van u, dan recht te doen, en weldadigheid lief te hebben, en ootmoedig te wandelen met uw God?
Micha 6 vers 8
Democratie is de slechtste regeringsvorm op al die andere vormen na die van tijd tot tijd zijn uitgeprobeerd.
Winston Churchill
Zonder kennis van het verleden weten we in het heden geen weg te vinden.
Gerrit Holdijk (1944-2015)
HEERE, wie zal verkeren in Uw tent? Wie zal wonen op den berg Uwer heiligheid? Die oprecht wandelt, en gerechtigheid werkt, en die met zijn hart de waarheid spreekt.
Psalm 15 vers 1 en 2
Jezus Christus zal in doodsnood zijn tot het einde der tijden. Gedurende die tijd moeten wij niet slapen.
Blaise Pascal
De inherente ondeugd van het kapitalisme is het ongelijk verdelen van zegeningen; de inherente deugd van socialisme is het gelijk verdelen van ellende.
Winston Churchill
Want door [Jezus Christus] zijn alle dingen geschapen, die in de hemelen en die op de aarde zijn, die zichtbaar en die onzichtbaar zijn, hetzij tronen, hetzij heerschappijen, hetzij overheden, hetzij machten; alle dingen zijn door Hem en tot Hem geschapen.
Kolossensen 1 vers 16
God is ons een Toevlucht en Sterkte; Hij is krachtelijk bevonden een Hulp in benauwdheden. Daarom zullen wij niet vrezen, al veranderde de aarde haar plaats, en al werden de bergen verzet in het hart der zeeën.
Psalm 46 vers 2 en 3
Als ik wist dat morgen de wereld zou vergaan, zou ik toch vandaag nog een appelboompje planten.
Maarten Luther (1483-1546)
De hemelen vertellen Gods eer, en het uitspansel verkondigt Zijner handen werk.
Psalm 19 vers 1
De rechtvaardigheid van de belastingtarieven interesseert God evenzeer, zo niet meer, als de aanhankelijkheid van een bevindelijke ziel.
A. A. van Ruler
Alle goede gave, en alle volmaakte gift is van boven, van de Vader der lichten afkomende, bij Wie geen verandering is, of schaduw van omkering.
Jakobus 1 vers 17
Omdat Jezus Christus alle macht in hemel en op aarde heeft, is Hij ook Heer van de overheid. De overheid móet Christus dienen, of ze nu wil of niet.
Dietrich Bonhoeffer (1906-1945)
Indien het mogelijk is, zoveel in u is, houdt vrede met alle mensen.
Romeinen 12 vers 18
Als je van het Evangelie gelooft wat je bevalt en verwerpt wat je niet bevalt, is het niet het Evangelie dat je gelooft, maar jezelf.
Aurelius Augustinus (354-430)